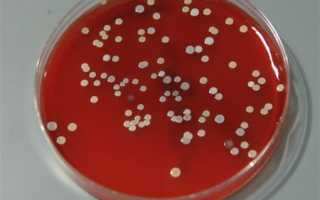

Под понятием культивирование бактерий, которое использует микробиология, подразумевается процесс выделения отдельных типов, видов либо клонов микроорганизмов. Благодаря естественным и искусственным субстратам можно получать комбинации из различных микроорганизмов.
Когда возникает потребность в чистых культурах?
Под чистыми культурами подразумевается набор бактерий, которые относятся к одному виду и обладают сходными культуральными, химическими и морфологическими характеристиками.
Применяться такие культуры могут в следующих случаях:
- При необходимости изучить систематику и переменчивость отдельных бактерий.
- При необходимости диагностировать инфекционное заболевание.
- В промышленных целях – в виде сырья для создания антибиотиков, витаминных и ферментных препаратов, гормонов стероидного типа, вакцин и прочих продуктов.
- В пищевой промышленности – в виде сырья для производства пива, вина, создания хлебобулочной и молочной продукции.
Чтобы получить чистые культуры отдельных микроорганизмов, применяются следующие методы: капельная технология Линднера, метод Ганзена с использованием влажной камеры, метод выделения из единой колонии на желатиновой либо агарной среде и микроманипуляторный метод.
Врачи подчеркивают, что культивирование и выделение аэробных и анаэробных бактерий требует особого подхода и тщательной подготовки. Аэробные бактерии, нуждающиеся в кислороде для роста, обычно изолируются на питательных средах, содержащих воздух, что позволяет им развиваться в оптимальных условиях. В то же время анаэробные бактерии, которые не переносят кислород, требуют создания бескислородной среды, что может быть достигнуто с помощью специальных анаэробных камер или добавления редуцирующих агентов в питательные среды. Врачи отмечают, что правильный выбор среды и условий культивирования критически важен для получения достоверных результатов. Кроме того, важно учитывать, что некоторые бактерии могут быть чувствительны к изменениям температуры и pH, что также требует внимательного контроля. В конечном итоге, успешное выделение этих микроорганизмов играет ключевую роль в диагностике и лечении инфекционных заболеваний.

Какие среды могут использоваться для культивирования аэробов?
Аэробы представляют собой микроорганизмы, для размножения и жизнедеятельности которых требуется кислород в свободном виде.
Современная микробиология предполагает принципы выделения аэробов на сложных и простых, полужидких, жидких, а также твердых питательных средах.
Среди самых распространенных простых питательных сред – мясопептонный агар, молоко, пептонная вода, картофельные ломтики, мясопептонный бульон.
Сложные среды представлены в виде простых составов, разбавленных специальными добавками – животной сывороткой, кровью, асцитической жидкостью и т.п.
Среды, в зависимости от целей дальнейшего использования микроорганизмов, подразделяют на следующие виды:
- Элективные. К таким средам относятся те, на которых рост аэробных и анаэробных микроорганизмов происходит значительно интенсивнее.
- Среды накопления (обогащения) дают возможность накопить либо же изолировать определенную разновидность бактерий. К данной группе относятся такие питательные среды, как среды Мюллера, Кауфмана и Килиана, благодаря которым удается изолировать распространение дифтерийных, паратифозных, тифозных и кишечных микроорганизмов.
- Дифференциально-диагностические среды. Их применяют при необходимости дифференцирования разновидности исследуемого микроорганизма, а также определения его качественных характеристик.
- Консервирующие среды, состоящие из веществ (к примеру, глицерина), благодаря которым имеется возможность в процессе транспортировки сохранять в живом виде патогенные микроорганизмы.
Какими методами выполняют культивирование?
В микробиологии выведение бактерий аэробного типа может происходить в следующих условиях:
- Условия, для которых берутся плотные питательные среды либо прослойка жидкой среды, в которой получение кислорода происходит из окружающего воздуха.
- Условия, при которых размножение происходит в питательных жидких средах (глубинный метод культивирования). Получение кислорода микроорганизмами в данном случае происходит из растворенных растворенных в жидкости молекул. Чтобы при низком содержании кислорода бактерии аэробного типа росли более интенсивно, жидкость потребуется аэрировать.
Используя такие методы, можно получить чистые аэробные культуры, используемые для разнообразных целей не только в медицине, но и промышленной и пищевой индустрии.
Культивирование и выделение аэробных и анаэробных бактерий — это важные процессы в микробиологии, которые имеют свои особенности и нюансы. Люди, работающие в этой области, отмечают, что аэробные бактерии требуют кислорода для роста, поэтому их культивирование обычно происходит в открытых системах или с использованием специальных условий, обеспечивающих доступ воздуха. В то же время анаэробные бактерии, напротив, thrive в бескислородной среде, что требует применения анаэробных камер или специальных питательных сред, которые исключают кислород.
Специалисты подчеркивают, что правильный выбор среды и условий для роста критически важен для получения чистых культур. Также важно учитывать, что анаэробные бактерии могут быть чувствительны к кислороду, что делает их выделение более сложным процессом. В результате, опытные микробиологи часто делятся своими методами и хитростями, чтобы обеспечить успешное культивирование обеих групп бактерий, что в свою очередь способствует развитию медицины, экологии и промышленности.

Культивирование микроорганизмов-анаэробов: основные особенности
Анаэробы представляют собой микроорганизмы, развитие и деление которых происходит в среде, не содержащей кислород в свободном виде. Обнаруживаются они практически во всех человеческих тканях, пробы берутся из воспалительно-гнойных очагов.
Принципы выращивания анаэробных микроорганизмов представляют собой более длительную и хлопотную процедуру, чем культивирование аэробных форм. Связано это с тем, что контакт культур с кислородом нужно свести к минимуму. Чтобы анаэробные условия были правильными, применяются разные методы, которые условно разделяются на биологические, химические и физические. Несмотря на свои особенности, все они имеют один сходный принцип – обеспечение замкнутого пространства.
Под физическими методами культивирования подразумевается выращивание микроорганизмов посредством микроанаэростата. В данном вакуумном агрегате вместо воздуха применяется газовая смесь.
К химическим методикам культивирования можно отнести:
- Методы, при которых используются химические вещества, способные поглощать кислородные молекулы. Для реализации в лабораторных условиях берутся хлорид меди одновалентной, раствор пирогаллола щелочной, дитионит натрия, а также другие реактивы.
- Метод, для которого используются восстанавливающие агенты, добавляемые с целью уменьшения окислительно-восстанавливающего эффекта среды. Происходить это может благодаря аскорбиновой кислоте, цистеину, тиогликолату натрия.
Что касается биологических способов размножения бактерий, то для их выполнения применяется, к примеру, чашка Петри, разделенная на две половины посредством желобка. В одной из половин помещаются анаэробные, а в другой – аэробные микроорганизмы, после чего края чаши заливаются парафином. Как только аэробы используют весь кислород, активируется рост анаэробных организмов.
Для культивирования молочнокислых бактерий могут применяться и другие способы:
- Посев в высокие слоя питательных сред.
- Размножение в плотных средах (с самой их толще).
- Метод размножения в вязких условиях, при которых процесс диффузии кислородных молекул в жидкость снижается при повышении ее плотности.
- Культивирование при помощи вазелинового масла либо стерильного парафина, заливаемого в питательную среду.
При наличии необходимых навыков, оборудования и реактивов, выделение анаэробных и других бактерий можно проводить и в домашних условиях.
Вопрос-ответ

Как культивируют анаэробные бактерии?
Культивирование анаэробов. Для культивирования анаэробов используются специальные питательные среды с добавлением веществ, редуцирующих содержащийся в среде кислород.
Что такое культивирование анаэробных бактерий?
Культивирование анаэробных бактерий: для них требуется пониженное содержание O2 в питательной среде, и они удаляют весь кислород, уже присутствующий в среде. 1. Специальные анаэробные питательные среды (предварительно восстановленные среды). 2. Анаэробные камеры. 3.
Как культивируют аэробы?
Наиболее простой и широко распространенный в лабораторной практике способ глубинного культивирования — выращивание на качалках, обеспечивающих встряхивание или вращение колб или пробирок со скоростью 100–200 об/мин и более.
Советы
СОВЕТ №1
Перед началом работы с бактериями обязательно ознакомьтесь с их характеристиками и требованиями к условиям культивирования. Аэробные бактерии требуют кислорода для роста, в то время как анаэробные могут развиваться в его отсутствии. Убедитесь, что у вас есть необходимое оборудование для создания соответствующей среды.
СОВЕТ №2
Используйте стерильные методы при работе с культурами, чтобы избежать контаминации. Это включает в себя использование стерильных инструментов, посуды и среды, а также соблюдение правил асептики во время работы с образцами.
СОВЕТ №3
При выделении анаэробных бактерий рассмотрите возможность использования анаэробных камер или пакетов, которые обеспечивают отсутствие кислорода. Это поможет создать оптимальные условия для роста и размножения этих микроорганизмов.
СОВЕТ №4
Регулярно контролируйте условия культивирования, такие как температура, pH и уровень кислорода, чтобы обеспечить стабильный рост бактерий. Используйте соответствующие индикаторы и приборы для мониторинга этих параметров.